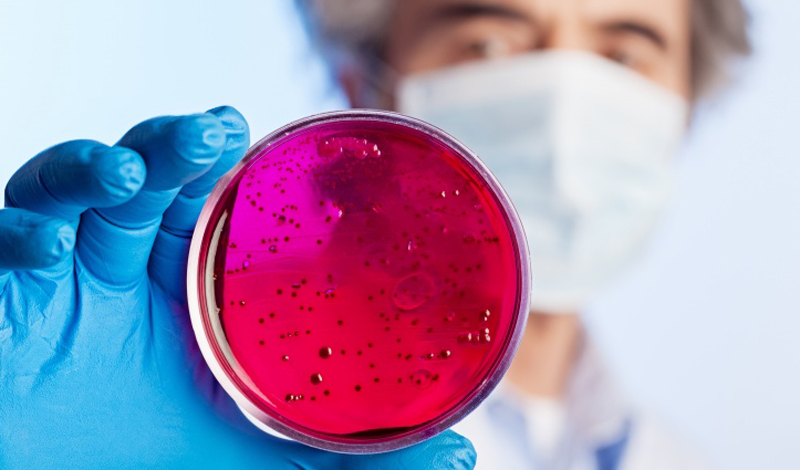
Секретные эксперименты, правда о которых появилась в истории

Секретные эксперименты, правда о которых появилась в истории
В большинстве своем ученые являются подлинными героями. Они, в конце концов, решают все проблемы мира — от изобретения пастеризации и рентгеновского аппарата, до ядерных боеголовок и космических путешествий. Но наука, безусловно, имеет и свою темную сторону. Без сдерживающего фактора этики, некоторые исследователи заходят слишком далеко. Вот, к примеру, несколько действительно пугающих экспериментов, которые долгое время оставались под грифом секретно.

Доктор Роберт Дж. Уайт был одержим мозгами. Нейрохирург из Кливленда был первым из американских врачей, кто во всеуслышание объявил мозговую ткань физическим хранилищем человеческой души. В 1970 году Уайт провел один из самых громких экспериментов всех времен и народов: взял и пересадил голову одной макаки другой. Правда, на ту пору США предпочли результаты работы оставить засекреченными. Однако, сравнительно недавно Уайт свои публикации представил на суд общественности. Он и в самом деле добился немалых успехов: обезьяна с пересаженной головой могла жить несколько дней после операции.

Неподалеку от залива Чесапик в Мэриленде расположена военная база США Edgewood Arsenal. С 1955 по 1975 год эта база была домом для тысяч испытаний, где вместо морских свинок выступали люди. Около 7000 добровольцев подписались к участию в программе «Эджвуд». Им обещали полную безопасность, к тому же, это было идеальным способом избежать военной службы во Вьетнаме. На самом деле ученые проверили на несчастных чуть ли ни каждое существовавшее химическое соединение. Одурманенные ЛСД солдаты сражались с невидимым противником, затем накачивались барбитуратами и погружались в длительные сновидения. На них даже использовали химические газы, такие как зарин.

С 1978 по 1996 Тед Качинский послал 16 замаскированных бомб в различные университеты и аэропорты. Прозванный прессой Unabomber человек сделал все это не просто так. По недавно рассекреченной информации, в 1959 году Качинский участвовал в странном психологическом эксперименте, проводившемся гарвардскими профессорами. В рамках испытания несчастного студента привязывали к стулу, подводили к его ногтям электроды и ослепляли прожекторами. При таких условиях Тед должен был продолжать отстаивать свои убеждения перед военным трибуналом — таким образом экспериментаторы пытались понять, как далеко должны зайти пытки, чтобы расколоть солдата противника. Естественно, после серии взрывов вся информация о Унабомбере была тщательно скрыта.

Во времена холодной войны правительственные чиновники США хотели понять, какие города были наиболее восприимчивы к биологическим атакам. Ничего лучшего, чем устроить «учебный эксперимент» им в голову не пришло и в 1950 году флот направил в залив у Сан-Франциско катер с грузом зараженных пробирок. Для эксперимента был выбран якобы безвредный микроб Serratia marcescens, распространение которого можно было легко отследить благодаря красным пигментным пятнам, появляющимся у зараженных. К сожалению оказалось, что микроб не совсем безвреден. Всего за 11 дней операции заразилось более 800 000 граждан Сан-Франциско, около тысячи погибли от инфекции дыхательных путей.

Дональд Юэн Кэмерон имел репутацию профессионального психиатра. Это потому, что мало кто был осведомлен об экспериментах, которые проводились Кэмероном в клинике Allan Memorial. Врач пытался излечить шизофрению, но действовал такими странными и жесткими методами, что они больше напоминали пытку. Накачивая пациентов ЛСД, Кэмерон привязывал их к кроватям и применял электросудорожную терапию. В конце концов, методы врача привлекли внимание ЦРУ и он был включен в печально известную программу MKULTRA. После окончания программы Кэмерон ушел на покой — никакого наказания за свои действия врач не понес.

Пересадка головы обезьяны
Доктор Роберт Дж. Уайт был одержим мозгами. Нейрохирург из Кливленда был первым из американских врачей, кто во всеуслышание объявил мозговую ткань физическим хранилищем человеческой души. В 1970 году Уайт провел один из самых громких экспериментов всех времен и народов: взял и пересадил голову одной макаки другой. Правда, на ту пору США предпочли результаты работы оставить засекреченными. Однако, сравнительно недавно Уайт свои публикации представил на суд общественности. Он и в самом деле добился немалых успехов: обезьяна с пересаженной головой могла жить несколько дней после операции.

Эксперименты Эджвуд
Неподалеку от залива Чесапик в Мэриленде расположена военная база США Edgewood Arsenal. С 1955 по 1975 год эта база была домом для тысяч испытаний, где вместо морских свинок выступали люди. Около 7000 добровольцев подписались к участию в программе «Эджвуд». Им обещали полную безопасность, к тому же, это было идеальным способом избежать военной службы во Вьетнаме. На самом деле ученые проверили на несчастных чуть ли ни каждое существовавшее химическое соединение. Одурманенные ЛСД солдаты сражались с невидимым противником, затем накачивались барбитуратами и погружались в длительные сновидения. На них даже использовали химические газы, такие как зарин.

Эксперименты Гарварда
С 1978 по 1996 Тед Качинский послал 16 замаскированных бомб в различные университеты и аэропорты. Прозванный прессой Unabomber человек сделал все это не просто так. По недавно рассекреченной информации, в 1959 году Качинский участвовал в странном психологическом эксперименте, проводившемся гарвардскими профессорами. В рамках испытания несчастного студента привязывали к стулу, подводили к его ногтям электроды и ослепляли прожекторами. При таких условиях Тед должен был продолжать отстаивать свои убеждения перед военным трибуналом — таким образом экспериментаторы пытались понять, как далеко должны зайти пытки, чтобы расколоть солдата противника. Естественно, после серии взрывов вся информация о Унабомбере была тщательно скрыта.
Операция Sea-Spray
Во времена холодной войны правительственные чиновники США хотели понять, какие города были наиболее восприимчивы к биологическим атакам. Ничего лучшего, чем устроить «учебный эксперимент» им в голову не пришло и в 1950 году флот направил в залив у Сан-Франциско катер с грузом зараженных пробирок. Для эксперимента был выбран якобы безвредный микроб Serratia marcescens, распространение которого можно было легко отследить благодаря красным пигментным пятнам, появляющимся у зараженных. К сожалению оказалось, что микроб не совсем безвреден. Всего за 11 дней операции заразилось более 800 000 граждан Сан-Франциско, около тысячи погибли от инфекции дыхательных путей.

Промывание мозгов
Дональд Юэн Кэмерон имел репутацию профессионального психиатра. Это потому, что мало кто был осведомлен об экспериментах, которые проводились Кэмероном в клинике Allan Memorial. Врач пытался излечить шизофрению, но действовал такими странными и жесткими методами, что они больше напоминали пытку. Накачивая пациентов ЛСД, Кэмерон привязывал их к кроватям и применял электросудорожную терапию. В конце концов, методы врача привлекли внимание ЦРУ и он был включен в печально известную программу MKULTRA. После окончания программы Кэмерон ушел на покой — никакого наказания за свои действия врач не понес.


Посетители, находящиеся в группе Гости, не могут оставлять комментарии к данной публикации.